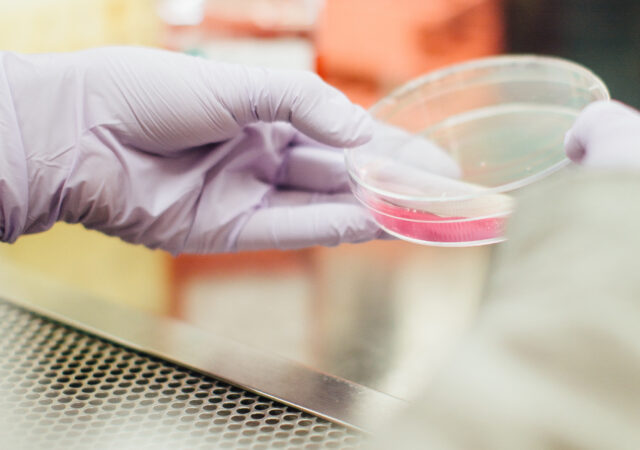

With guest Jackie Meyer
Faith’n’Family – Building a Strong and Faithful Family: Singing Together
With guest Rev. Phil Hoppe
Faith’n’Family – Theological Topics in a Scientific Age
With guest Rev. Dr. Joel Okamoto
Faith’n’Family – LCMS Resources: “13 Reasons Why”
With guests Rev. Mark Kiessling, Rev. Dr. Lucas Woodford, Hannah Leftwich, and Jamie Walters
Faith’n’Family – Rev. Chuck & Jean Hoffman, Serving the Lord in South Korea
With guest Rev. Chuck Hoffman
Faith’n’Family – Preventing Burnout in Church Vocations
With guests Rev. Dr. Darrell Zimmerman and Rev. Richard Snow
Faith’n’Family – Encouraging Youth to Consider Church Vocations
With guest Jeffrey S. Beavers, M.A., MFT
Faith’n’Family – Joyful Sound Children’s Choir
With guests Emily Woock and children from the Joyful Sound choir